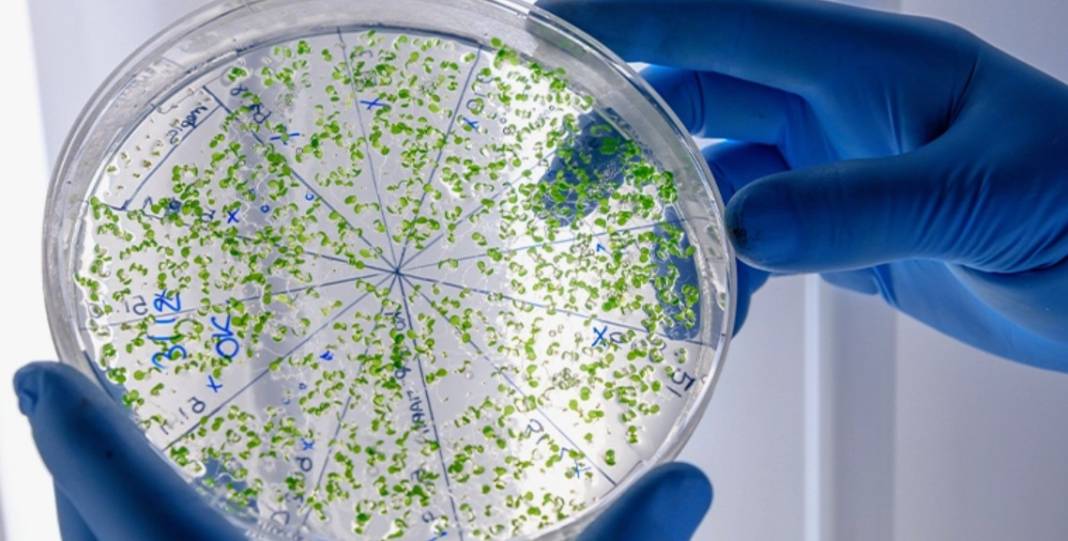

Cilt bakımında son trend: Ekzosomlar bir mucize mi, yoksa bir aldatmaca mı? Bilim insanları uyardı


Ekzosom serumlarının son yıllarda cilt bakım dünyasındaki popülerliği artmış durumda. ‘Şişedeki mikroiğneleme’ olarak tanımlanan bu yöntem, insan ve bitki kaynaklı olabilen nano boyutlu haberci hücrelerden oluşuyor. Bu hücrelerin cilde uygulandığında kolajen üretimini artırıp iltihap ve pigmentasyonu azaltabileceği iddia ediliyor. Fakat dermatologlar ve bilim insanları, bu ürünler konusunda temkinli olunması gerektiği konusunda uyarıyor.

EKZOSOM NEDİR?
Ekzosomlar, çoğu hücre tarafından salgılanan küçük, baloncuk benzeri yapılardır. İçlerinde protein, lipit, mRNA ve mikroRNA taşırlar ve hücreler arasında iletişimi sağlarlar. İlk kez 1980’lerde keşfedilen ekzosomlar, başlangıçta sadece hücresel atık olarak görülüyordu. Fakat sonraki yıllarda, hücre davranışlarını yönlendiren aktif haberci görevleri olduğu anlaşıldı.
Exoceuticals markasının rejeneratif tıp uzmanı Robin Smith, ekzosomları “paket teslim eden bir kargo gibi” tanımlıyor:
“Hücreye gidiyor, içerik ve nasıl kullanılacağını anlatan talimatları bırakıyor.”
Mayo Clinic’ten Saranya Wyles ise ekzosomların kaynağının önemli olduğunu belirtiyor:
“Kanserli veya iltihaplı hücrelerden gelen ekzosomlar zararlı olabilir, trombosit gibi rejeneratif hücrelerden gelenler ise faydalı sinyaller taşır.”

EKZOSOMLAR CİLTTE NASIL KULLANILIYOR?
Cilt bakımında kullanılan ekzosomlar, hücrelere daha fazla kolajen, elastin ve hyaluronik asit üretmeleri talimatı veriyor. İnsan dokusu (yağ dokusu, trombositler veya kök hücreler), bitkiler (cica, yeşil çay) ve bazı meyveler (greyfurt, karpuz) kaynaklı olabiliyor. Pahalı ürünlerde insan kaynaklı ekzosomlar bulunurken, daha uygun fiyatlı seçenekler bitki kaynaklı. İnsan ekzosomları, FDA uyumlu hücre bankalarından elde edilip laboratuvar ortamında çoğaltılıyor, ardından saflaştırılıp toz haline getiriliyor.

KANITLAR VE ETKİNLİK
Araştırmalar, ekzosomların cilt bakımında potansiyel sunduğunu gösterse de kanıtlar halen sınırlı. 2024 yılında yapılan bir çalışma, 56 yetişkin üzerinde topikal trombosit kaynaklı ekzosomların kullanımında, yüzde 87 oranında yüz derisinde iyileşme bildirildiğini gösterdi. Ama bu çalışmanın kontrol grubu yoktu ve gözlemlenen etkiler tamamen ürün kaynaklı olmayabilir. Histolojik incelemeler kolajen kalınlığında artış gösterse de cilt fonksiyonel olarak tam anlamıyla iyileşmiş sayılmıyor.
Jordan Glenn, “Bu sonuçlar umut verici, ama kontrollü ve kör çalışmalarla doğrulanması gerekiyor” diyor. Ekzosomların topikal olarak cilde nüfuz edip etmediği konusunda da halen araştırmalar sürüyor.
GÜVENLİK VE DÜZENLEME
FDA, insan kaynaklı ekzosomları biyolojik ilaçlar olarak sınıflandırıyor ve mikroiğneleme veya enjeksiyon ile tıbbi amaçlı kullanımını onaylamıyor. Topikal ürünlerde yasal olarak kullanılabiliyor ancak güvenlik ve etkinlik standartları endüstri genelinde net değil. Wyles, tüketicilere, ekzosom içerikli bir ürün almadan önce üretim ve test süreçlerini dikkatle araştırmalarını tavsiye ediyor:
“Birçok ürün, ekzosom miktarını doğrulamakta yetersiz.”